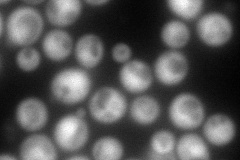
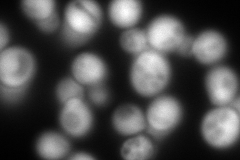
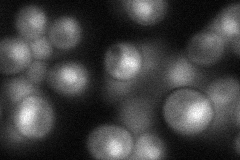
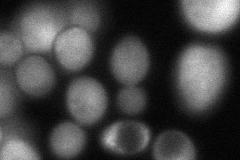
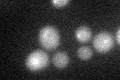

View description
Ubiquitin-like protein modifier, may function in modification of Sph1p and Hbt1p, functionally complemented by the human or S. pombe ortholog; mechanism of Hub1p adduct formation not yet clear
Localization:
Intensity:
Fold change:
Significance:
-
C’ GFP library in SD

below threshold12.76 -
N' NOP1pr-GFP in SD
cytosol256.066 -
N' TEF2pr-mCherry in SD
cytosol390.396 -
N' NATIVEpr-GFP in SD
nucleus53.0182 -
N' TEF2pr-VC and Cyto-VN in SD
cytosol77.507 -
C’ GFP library in SD+DTT
cytosol16.21.26No -
C’ GFP library in SD+H2O2

cytosol14.431.13No -
C’ GFP library in Starvation Media

cytosol17.31.35No -
C’ GFP library on the background of Pup2-DaMP

below threshold -
C’ GFP library on the background of CCT mutant

below threshold12.7390.997627No
